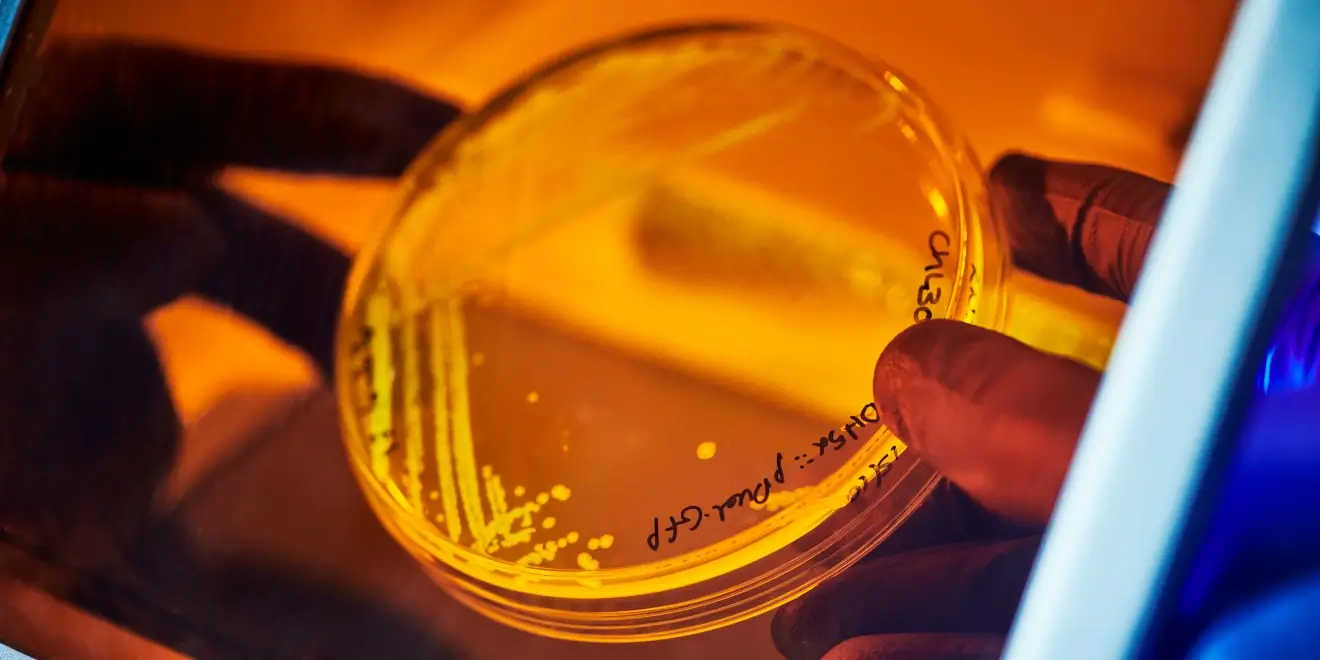

Incubators
The home of innovative science
and engineering companies
Incubators

VC
VC
Early-stage investment for Deep Tech startups — by founders, for founders

Platform
Training, expertise and resources to connect and empower Deep Tech
Platform

Outreach
Sparking curiosity in STEM and entrepreneurship across generations
Outreach



















.webp)